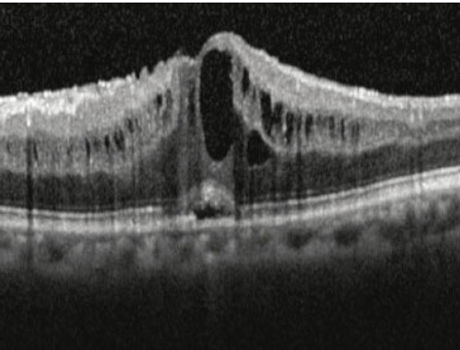
oct cme

top of page

Get expert opinion regarding
We provide expert opinion via online eye specialist consultation for
Fundus/Retina
Visual standards for competitive examination in india
Automated Perimetry/ Visual field analysis
Optical coherence tomography
Ultrasound B- scan
Fundus fluoroscein angiography
Anterior segment
Keratometry
A scan
Intra ocular lens power
Pentacam
Orbscan
Ultrasound biomicroscopy
specular microscopy
confocal microscopy
Fundus /retina images

Normal Fundus

Hypertensive retinopathy

Diabetic retinopathy

Centra retinal vein occlusion

Central retinal artery occlusion

Dry Age related macular degeneration

Retinopathy of prematurity

Advanced glaucoma on visual field analysis

Normal optical coherence tomography

Macular hole on OCT
Cystoid macular edema on OCT

Normal B scan ultrasonography

Retinal detachment on B scan

Choroidal neovascular membrane on Fundus fluoroscein angiography

Normal A scan

Normal pentacam
bottom of page
